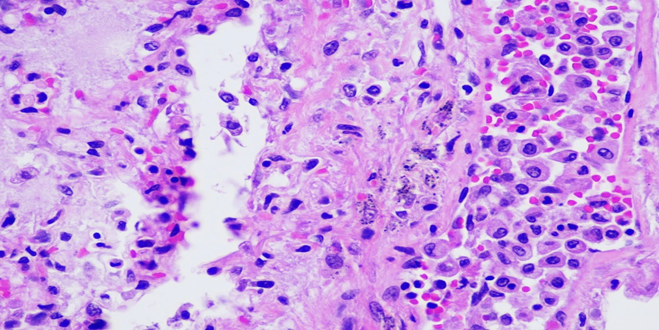
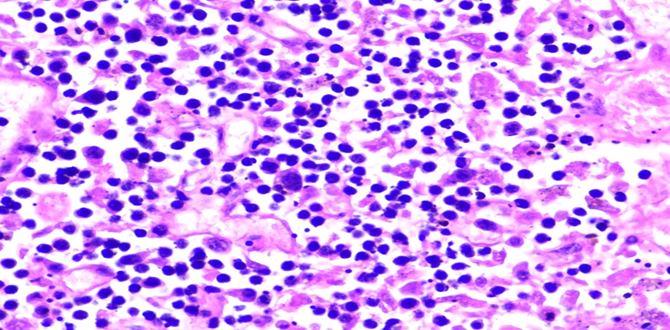
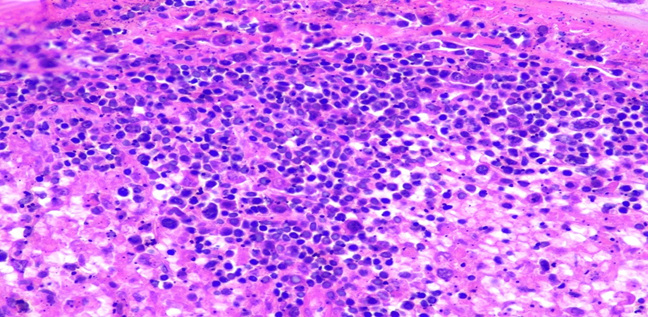
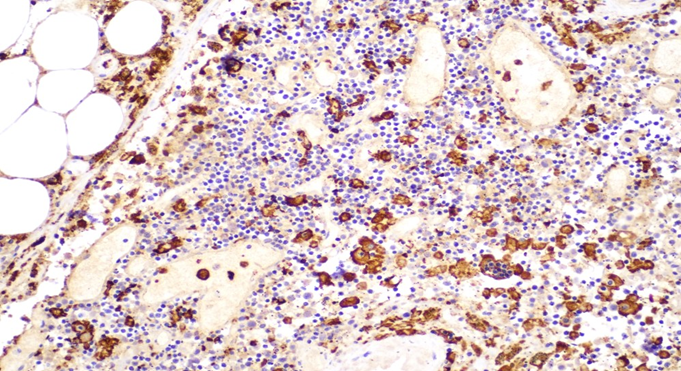

Autopsy Findings in a Case of Hemophagocytic Lymphohistiocytosis Presenting with Altered Mental Status
by Brandi Hull, D.O., Joshua Lee, M.D., Chukwuemeka-Chika Iguh, M.D., Caroline Yap, M.D., Truc Tran, M.D.*
Department of Pathology, Harbor UCLA Medical Center, 1000 W. Carson Street, Torrance, CA, 90502, USA
*Corresponding author: Truc Tran, Department of Pathology, Harbor UCLA Medical Center, 1000 W. Carson Street, Torrance, CA, 90502, USA
Received Date: 26 August 2025
Accepted Date: 29 August 2025
Published Date: 02 September 2025
Citation: Hull B, Lee J, Iguh C, Yap C, Tran T. (2025). Autopsy Findings in a Case of Hemophagocytic Lymphohistiocytosis Presenting with Altered Mental Status. Ann Case Report. 10: 2395. https://doi.org/10.29011/2574-7754.102395
Abstract
Hemophagocytic lymphohistiocytosis (HLH) is a rare, life-threatening hyperinflammatory syndrome characterized by excessive immune activation and cytokine release, often leading to multiorgan failure. A 66 year old male with a past medical history of hypertension, insulin dependent diabetes mellitus and prior back surgery was admitted to the hospital for progressive altered mental status over the past week. Despite aggressive medical intervention the patient was changed to comfort care and expired on 12/1/24. The autopsy gross examination revealed no significant findings, but histologic examination revealed widespread hemophagocytosis in the bone marrow, spleen, and lymph nodes. These findings were confirmed with immunohistochemical stains showing histiocytes positive for CD68 and CD163. This case met 6/8 of the HLH-2004 criteria confirming the diagnosis of HLH. The autopsy findings provided definitive evidence of HLH, emphasizing the importance of early recognition and treatment in such cases. This report highlights the role of autopsy in elucidating the underlying pathology in complex, multisystem diseases.
Case Summary: A 66 year old male with a history of hypertension, insulin dependent diabetes mellitus and prior L5/S1 spinal fusion in 2011 with revision of L5 screw presented for progressive altered mental status over the past week. He was intubated for airway protection in the emergency department and transferred to the ICU on 11/29/24 for fevers, altered mental status (AMS) and hypotension requiring pressors. Despite treatment the patient continued to decline and family decided to make the patient DNR. The patient was moved to comfort care at 1702 on 12/1/24. Patient was pronounced deceased at 1812 on 12/1/24.
Introduction
Hemophagocytic lymphohistiocytosis (HLH) is a syndrome of pathologic immune activation that can be either primary (familial) or secondary to triggers such as infections, malignancies, or autoimmune diseases. HLH is characterized by uncontrolled proliferation of activated lymphocytes and histiocytes with hemophagocytosis, leading to a cytokine storm and subsequent multiorgan failure. This report presents the autopsy findings in a 66 year old male whose clinical course was consistent with HLH.
Case Presentation
Patient Demographics: 66 year old male with a history of hypertension, insulin dependent diabetes mellitus and prior L5/S1 spinal fusion in 2011 with revision of L5 screw.
Clinical Course: Patient presented for progressive altered mental status over one week. He was intubated for airway protection in the emergency department and transferred to the ICU on 11/29/24 for altered mental status (AMS) work up and hypotension requiring pressors. Despite treatment the patient continued to decline and family decided to make the patient DNR. The patient was moved to comfort care 12/1/24. Patient was pronounced deceased at 1812 on 12/1/24. (Table 1).
|
Labs 12/1/24 |
Normal range |
|
|
WBC |
9.8 K/cumm |
4.5-10 |
|
Hgb |
(L) 8.7 g/dL |
13.5-16.5 |
|
Platelets |
(L) 21 K/cumm |
160-360 |
|
INR |
(!) 6.09 |
0.87-1.14 |
|
Bilirubin |
(L) <15 mg/dL |
0.1-1.2 |
|
AST |
(H) >4440 (U/L) |
15-41 |
|
ALT |
(H) 1,733 (U/L) |
14-54 |
|
Ferritin |
(H) >40000 ng/mL |
22-275 |
|
D-Dimer |
(H) >20.00 mcg/mL FEU |
<=0.49 |
|
Haptoglobin |
(L) <15 mg/dL |
36-195 |
|
Fibrinogen |
(L) 117 mg/dL |
215-450 |
|
Triglycerides |
(H) 190 mg/dL |
<=149 |
Table 1: Ante-mortem laboratory parameters of patient.
Indications for Autopsy: A complete autopsy was requested by the family to determine the precise cause of death.
Autopsy Procedure: Standard autopsy procedures were performed following informed consent and in compliance with institutional protocols. Both external and internal examinations were carried out, with representative tissue samples taken for histologic evaluation.
External Examination: The body was that of a well-nourished with large body habitus 66 year old male, measuring 169 cm in height and weighing 123.1 kg. No deformities or external traumatic injuries were noted. Mild icteric of the skin was noted with a 2.6cm well healed linear scar in the RLQ. Lividity to the upper extremities, upper back, bilateral legs and buttocks were observed. Sclerae with mild icteric and conjunctival swelling. Poor dentition with a gold tooth implant was identified. Symmetric livedo reticularis of bilateral lower extremities was noted.
Internal Examination
Cardiovascular System: The heart was slightly enlarged with a weight of 410 grams and increased right ventricle thickness of 0.5 cm. The mitral valve was 10.5 cm, the pulmonary valve was 9 cm and the aortic valve was 8.5 cm with moderate coronary atherosclerosis. Significant epicardial fat was identified. Coronary arteries had marked calcifying atherosclerosis with the left anterior descending artery showing atherosclerotic plaques occupying 60% of the lumen, the left circumflex showing atherosclerotic plaques occupying 30% of the lumen and the right coronary artery showing atherosclerotic plaques occupying 70% of the lumen. Of note the thoracic and abdominal aorta showed mild to moderate calcifying atherosclerosis.
Respiratory System
Trachea: Normal mucosa. No ulcerations, lesions, masses or obstruction. Minimal serous fluid present.
Bronchi: Normal mucosa. No ulcerations, lesions, masses or obstruction.
Lungs: Congested and large in size weighing 100 grams on the right and 1010 grams on the left; anthracotic pigment was present however, no evidence of infection or pulmonary embolism was identified. (Figure 1).

Figure 1: Gross view of left and right lung with congestion and anthrocotic pigment.
Abdominal Organs:
Esophagus: Normal mucosa. No ulcerations, varices, masses or lesions.
Stomach: Dark red mucosa at the antrum of stomach was noted.
Pancreas: Enlarged weighing 150 grams; however, was grossly normal in appearance.
Adrenal glands: Grossly normal in appearance.
Kidneys: Enlarged with the right kidney weighing 210 grams and the left weighing 200 grams.
Extensive scarring, thinned cortex, fibrotic and atrophied medulla with thickened and irregular surface on both the exterior and interior surface was observed in bilateral kidneys. Moderate atherosclerosis was noted.
Liver: Enlarged weighing 2240 g; however, was grossly normal in appearance. (Figure 2).

Figure 2: Gross view of liver with hepatomegaly.
Gallbladder: Dark green viscous bile present. No masses or lesions.
Spleen: Markedly enlarged weighing 300 g without lacerations, scarring, masses or lesions. (Figure 3).

Figure 3: Gross view of spleen with splenomegaly.
Lymph Nodes: Lymph nodes identified showed no masses or lesions.
Bone Marrow: Grossly normal in appearance.
Other Organs
The remaining organs and organ systems did not show specific pathologic changes directly attributable to HLH aside from congestion and mild edema.
Microscopic Findings:
Cardiovascular System: Right and left ventricular sections and interventricular septum display myocyte hypertrophy with nuclear hyperchromasia and box-like configuration. There are focal areas of fibrosis with fatty replacement of myocardium in right and left ventricle. Aortic valve and aortic arch show foci of calcification. LAD and RCA show calcifications and atherosclerotic plaques occluding around 80% of the lumen. LCX is patent with some mild wall thickening. Thoracic and abdominal aorta with calcifications. No thrombosis or occlusion.
Respiratory System: Sections of the right and left lungs show variable areas of vascular congestion, emphysematous changes, intraalveolar edema, and interstitial stromal acute and chronic and inflammation with focal interstitial fibrosis. Pleural fibrin adhesion and subpleural acute and chronic inflammation are identified. Clusters of intravascular histotypes identified, highlighted with CD68 and CD163. Granulomas, fungal forms, viral cytopathic effects, dysplasia, and malignancy are not seen. Special stains of GMS, GRAM, PAS and Iron support the findings. (Figures 4, 5A-C, 6A-D, 7A-C).
Figure 4: A photomicrograph of lung showing interstitial edema and intra-alveolar accumulation of mixed inflammatory infiltrates (H&E, 40X).
Figure 5A: Photomicrographs showing hemophagocytosis by macrophages in lymph node (H&E, 60X magnification).
Figure 5B: Photomicrographs showing hemophagocytosis by macrophages in bone marrow (H&E, 40X magnification).
Figure 5C: Photomicrographs showing hemophagocytosis by macrophages in spleen (H&E, 40X magnification).

Figure 6A: Photomicrographs highlighting macrophages in lymph node stained with CD68 (IHC, 20X magnification).
Figure 6B: Photomicrographs highlighting macrophages in lymph node stained with CD163 (IHC, 20X magnification).

Figure 6C: Photomicrographs highlighting macrophages in spleen stained with CD68 (IHC, 10X magnification).

Figure 6D: Photomicrographs highlighting macrophages in spleen stained with CD163 (IHC, 10X magnification).

Figure 7A: Photomicrograph highlighting macrophages in bone marrow stained with CD61 (IHC, 20X magnification).

Figure 7B: Photomicrograph highlighting macrophages in bone marrow stained with CD68 (IHC, 20X magnification).

Figure 7C: Photomicrograph highlighting macrophages in bone marrow stained with CD163 (IHC, 20X magnification).
Abdominal Organs:
Esophagus: Mucosa showing autolysis, but otherwise within normal limits.
Stomach: Mucosa showing autolysis and mild vascular congestion, but otherwise within normal limits.
Pancreas: Autolytic changes present.
Kidneys: H&E, PAS, and JSS stains of the left and right kidneys show renal parenchyma with no evidence of diabetic changes, scarring, or nephrosclerosis.
Liver: Significant autolytic changes. Mild cholestasis. Mild macrovesicular steatosis and mild portal lymphocytic infiltration. No significant iron deposition. No alpha-1-antitrypsin inclusions. No cirrhosis, or malignancy seen. Special stains of Trichrome, iron, PAS and Reticulin support the findings.
Gallbladder: Autolytic changes, otherwise within normal limits. No calculi identified.
Spleen: Tissue architecture and cellular morphology showing many hemophagocytic cells highlighted with CD68 and CD163.
Lymph Nodes: Paracortical expansion with numerous histiocytes actively phagocytosing hematopoietic elements. Hemophagocytic cells highlighted with CD68 and CD163.
Bone Marrow: Hypercellular marrow (70% cellularity) with trilineage hematopoiesis. Many hemophagocytic cells are identified. Trabecular bone is unremarkable. CD68 and CD163 highlights hemophagocytic activity. CD61 highlights megakaryocytes. Iron: minimal iron storage; could be suboptimal due to decalcification of bone.
Final Autopsy Diagnosis:
I. Hemophagocytic lymphohistiocytosis (HLH) (meets 6/8 criteria)
a. Clinical findings of:
i. Fever ii. Hypofibrinogenemia (117 mg/dL; 12/1/2024) iii. Hyperferritinemia (>40000 ng/mL;12/1/2024) iv. Cytopenias (Hgb 8.7 g/dL and Platelets 21 K/cumm; 12/1/2024)
v. Elevated IL2 receptor (CD25) (47375 pg/mL)
b. Histologic findings:
- Evidence of hemophagocytosis in the bone marrow, spleen and lymph node
- Clusters of intravascular histiocytes in the pulmonary system identified
II. Clinical findings of septic shock (per chart patient meets 3/4
SIRS criteria)
- Sputum culture: Positive for Escherichia coli and Candida albicans (11/30/2024)
b. R. typhi IgM and IgG detected (titers >= 1:256); confirmed with realtime PCR (California Department of Public Health)
- Elevated Mycoplasma IgG titers (0.94 - equivocal)
III. Cardiovascular system
- Heart weight: 410 grams
- Focal calcification in the aortic valve
- Atherosclerotic calcification identified in left anterior descending artery (60%), left circumflex artery (30%) and right coronary artery (70%)
- Moderate patchy atherosclerosis of the descending and abdominal aorta with severe calcification (plaque-forming), no evident dissection
IV. Respiratory system (Right lung 1000 Grams; Left lung 1010
Grams)
- Pulmonary congestion bilaterally with pulmonary edema and interstitial inflammation and fibrosis
- Clusters of intravascular histiocytes
V. Liver
- Hepatomegaly (Wt: 2240 grams)
- Mild macrosteatosis
- Cholestasis
Discussion
Hemophagocytic lymphohistiocytosis (HLH) is a rare but highly lethal hyperinflammatory syndrome characterized by aberrant activation of cytotoxic T-cells and macrophages, leading to excessive cytokine release and multi-organ destruction [1,3,5]. HLH can present as either a primary (genetic) or secondary (acquired) disorder [1,3,5]. In adults, secondary HLH is often associated with infections (notably EBV), malignancies (especially T-cell or NKcell lymphomas), and autoimmune conditions [3,4,6].
This case highlights the diagnostic challenges associated with HLH, particularly in adult patients, where clinical signs often overlap with sepsis or malignancy-related cytokine storms [3,4,6]. Despite fulfilling several HLH-2004 criteria, including hyperferritinemia, cytopenias, and evidence of hemophagocytosis on bone marrow and splenic histology, the diagnosis was not made until post-mortem [1,2]. Autopsy findings included splenomegaly with extensive hemophagocytosis, hepatic sinusoidal histiocytosis, and reactive lymphadenopathy, consistent with advanced HLH (9,10). These findings emphasize the systemic nature of the disease and the role of autopsy in confirming a diagnosis when ante-mortem suspicion is low [10,11]. (Table 2).
Known immunosuppression | No (0) | Yes (18) |
Temperature (℃) | <38.4 (0) | 101.1-102.9 (38.4-39.4) (33) |
Organomegaly | No (0) | Hepatomegaly and splenomegaly (38) |
Number of cytopenias | 1 lineage (0) | 3 lineages (34) |
Ferritin (ng/mL) | <2,000 (0) | >6,000 (50) |
Triglycerides (mg/dL) | <132.7 (0) | 132.7-354 (44) |
Fibrinogen (mg/dL) | >250 (0) | <250 (30) |
AST (U/L) | <30 (0) | <30 (19) |
Hemophagocytosis features on bone marrow aspirate | No (0) | Yes (35) |
Probability of hemophagocytic syndrome | >99% (283 points) |
Table 2: HS Score for decedent. Categories in bold is the decedent’s score.
Histologically, the presence of activated histiocytes engulfing erythroid, myeloid, and platelet precursors across multiple organs serves as a diagnostic hallmark [1,5]. However, hemophagocytosis is neither sensitive nor specific in early disease and may be absent in initial biopsies [1,3]. The delay in clinical recognition and lack of immediate initiation of HLH-directed therapy (e.g., dexamethasone, etoposide) and the original HLH trigger likely contributed to the fulminant disease course in this patient [1,3,4].
Clinically, the patient presented with nonspecific but severe systemic manifestations, including persistent fever, cytopenias, hepatosplenomegaly, and progressive multiorgan dysfunction [3,4,6]. These features are consistent with the clinical phenotype of hemophagocytic lymphohistiocytosis, yet they overlapped with more common differential diagnoses such as sepsis, disseminated malignancy, or autoimmune flares [3,4]. Laboratory evaluation revealed markedly elevated ferritin and liver function abnormalities, both of which are frequently reported in HLH and correlate with the cytokine-driven hyperinflammatory state [3,4,5]. Rickettsia typhus was suspected and sent for out testing during the clinical course on 11/21/24. Despite these red flags, the diagnosis was not established during life, underscoring the diagnostic difficulty of HLH in adults and the need for quicker turnaround times for send out laboratory testing [3,4,6]. In this case, postmortem identification of Salmonella Typhi strongly suggests that typhoid fever may have served as the inciting event for secondary HLH. Although viral agents remain the most frequent triggers of HLH, S. Typhi an intracellular pathogen has been implicated in both adult and pediatric HLH cases. For instance, one report describes a 24-year-old man with fever, altered mental status, rash, gastrointestinal bleeding, and confirmed hemophagocytosis on bone marrow examination in the context of complicated typhoid fever [3]. Another describes a 21-year-old woman who developed HLH and rhabdomyolysis during typhoid fever [6]. Even pediatric cases such as a four-year-old with fever, diarrhea, pancytopenia, and HLH diagnosed via bone marrow biopsy support this association [7]. A literature review including patients from non-endemic regions also documented consistent clinical features including prolonged fever and cytopenias demonstrating that this is a global, albeit rare, phenomenon [8]. The pathophysiology likely involves persistent intracellular infection with S. Typhi, leading to dysregulated activation of macrophages and T-lymphocytes, culminating in the cytokine storm and hemophagocytosis. This suggests that early recognition of HLH in typhoid patients especially those with unremitting fever, cytopenias, and multiorgan dysfunction could be life-saving when combined with targeted immunomodulatory therapies.
Conclusion
This case reinforces the importance of a multidisciplinary approach and the utility of applying HLH scoring systems (such as HScore) in patients with unexplained systemic inflammatory response, especially in those with risk factors like recent infections, malignancy, or autoimmune disease. Autopsy played a pivotal role in confirming the diagnosis, providing closure for the clinical team, and contributing to quality improvement by identifying a missed diagnosis. HLH should be considered in any patient with unexplained multiorgan dysfunction, cytopenias, and elevated inflammatory markers, especially when initial infectious workups are negative. Early identification and prompt treatment are paramount, and this case serves as a powerful reminder of the diagnostic value of autopsy in modern medicine.
Acknowledgments
We would like to thank the staff, faculty, resident physicians and the decedent’s family that helped contributed to this publication and learning opportunity.
Conflict of Interest Statement
This autopsy was conducted in the absence of any commercial or financial relationships that could be construed as a potential conflict of interest.
References
- Zayed Y, Osman M, Kheiri B, Azher Q, Bachuwa G. (2018). Bilateral pulmonary nodules and intravascular pulmonary histiocytosis: A rare presentation of hemophagocytic lymphohistiocytosis secondary to Epstein-Barr Virus infection. Respir Med Case Rep. 26: 11-13.
- Ponnatt TS, Lilley CM, Mirza KM. (2022). Hemophagocytic lymphohistiocytosis. Archives of Pathology & Laboratory Medicine, 146: 507-519.
- Hutchinson M, Tattersall R, Manson J. (2019). Haemophagocytic lymphohisticytosis-an underrecognized hyperinflammatory syndrome. Rheumatology (Oxford, England). 58: vi23-vi30.
- Reddy R, Borah S, Singh N, Barua D. (2024). Hemophagocytic lymphohistiocytosis secondary to complicated typhoid fever: a case report. Oxford Med Case Reports. 2024: omae151.
- Barman B, Kataki M, Sharma JD, Deka P, Deka D. (2018). Infectionassociated hemophagocytic lymphohistiocytosis: A case report of typhoid associated HLH. J Family Med Prim Care. 7: 630-632.
- Ghosh S, Khurana A, Bhattacharya A, Singh S. (2015). Typhoid fever complicated by hemophagocytic lymphohistiocytosis and rhabdomyolysis: a case report. Am J Trop Med Hyg. 93: 1068-1070.
- Herreros B, García-Burguillo A, Álvarez A. (2019). Typhoid fever causing haemophagocytic lymphohistiocytosis in a non-endemic country: First case report and review of the current literature. Enferm Infecc Microbiol Clin. 37: 700-703.
- Henter JI, Horne A, Aricó M. (2007). HLH-2004: Diagnostic and therapeutic guidelines for hemophagocytic lymphohistiocytosis. Pediatr Blood Cancer. 48: 124-131.
- Fardet L, Galicier L, Lambotte O. (2014). Development and validation of the HScore, a score for the diagnosis of reactive hemophagocytic syndrome. Arthritis Rheumatol. 66: 2613-2620.
- Palanisamy A, Subramanian S, Rangarajan R, Kannan P, Chidambaram B. (2019). The role of autopsy in hemophagocytic lymphohistiocytosis: A case series and review of the literature. Indian J Pathol Microbiol. 62: 607-611.
- Buhr T, Bode U, Fuchs D. (2001). Severe hemophagocytic lymphohistiocytosis in children and adolescents-Diagnostic relevance of bone marrow and autopsy findings. Virchows Arch. 439: 200-207.
© by the Authors & Gavin Publishers. This is an Open Access Journal Article Published Under Attribution-Share Alike CC BY-SA: Creative Commons Attribution-Share Alike 4.0 International License. Read More About Open Access Policy.